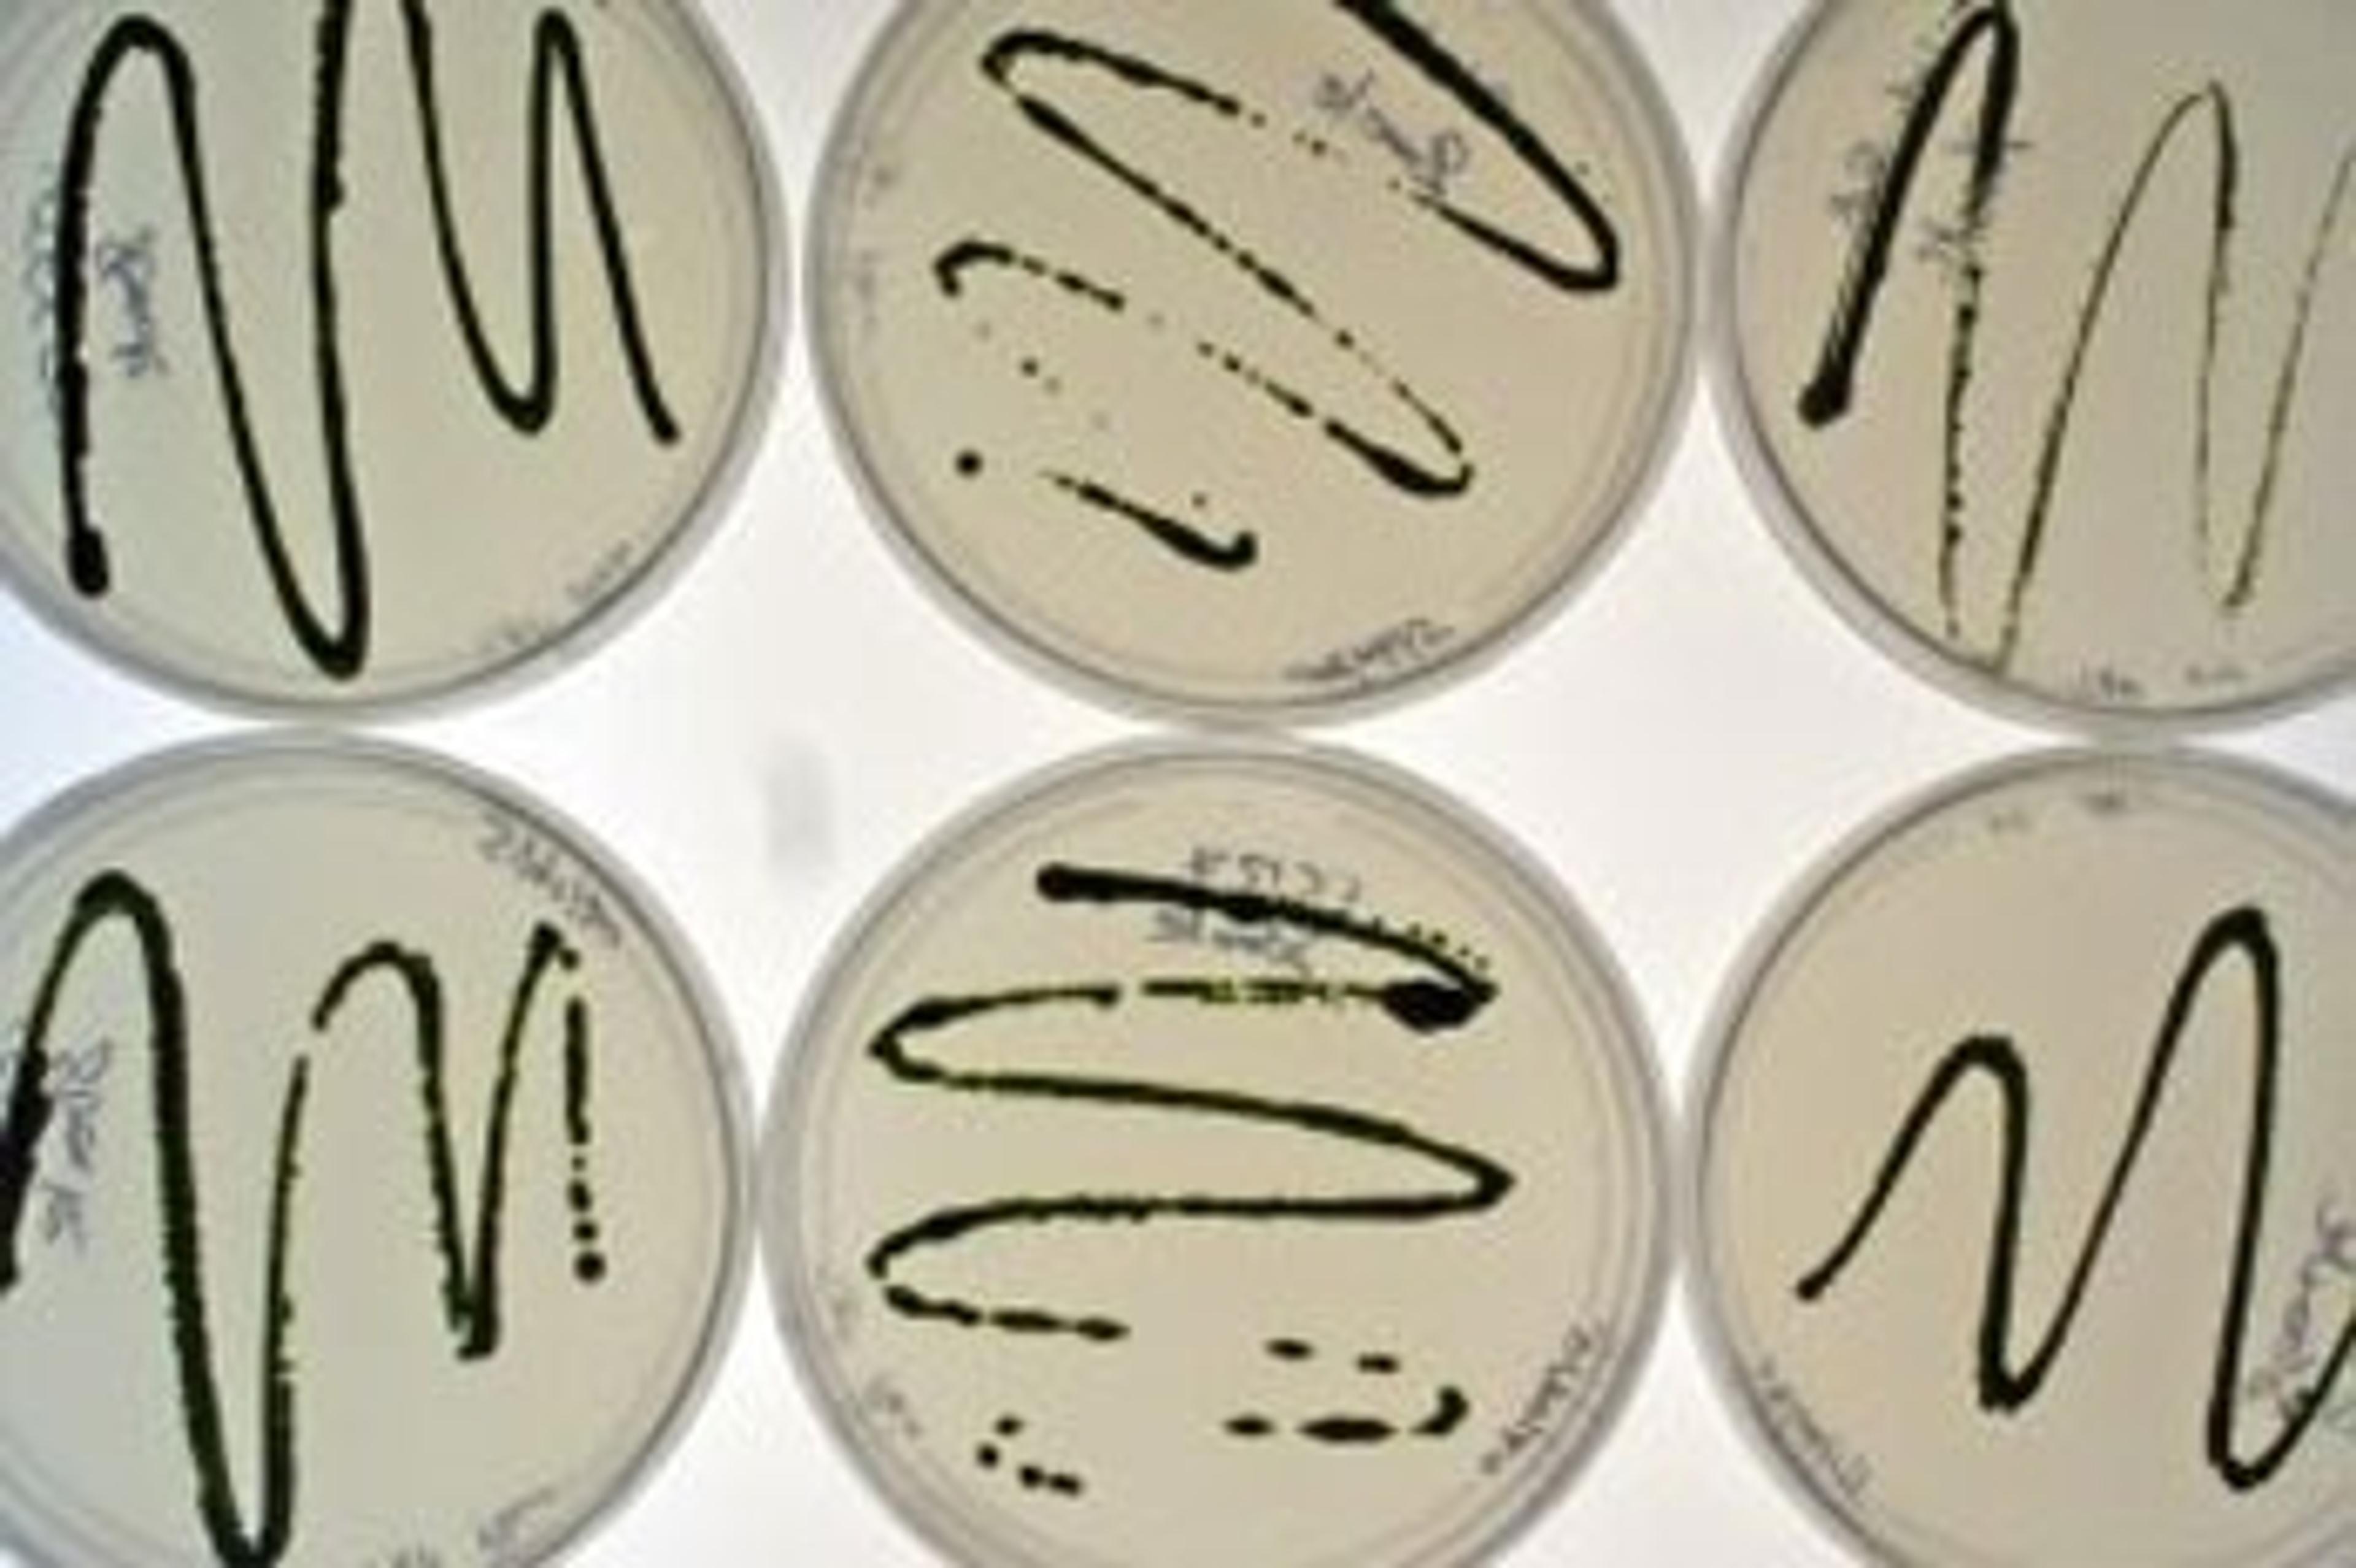

News & Articles
Electrically Charged Crinkles in Graphene Could Lead to Breakthroughs in Nanotechnology
Gently compressed stacks of graphene form sharp crinkles that carry an electric charge, which could be useful in nanoscale self-assembly and other applications
Powering Wearable Sensors with Solar Supercapacitor
New solar-powered supercapacitor could help make future wearable technologies lighter and more energy-efficient
Natural Chromium Sources Threaten California Groundwater, Stanford Scientists Find
Natural sources of the toxic form of chromium appear in wells that provide drinking water to a large population in California, offering a new perspective on California’s groundwater management challenges
Glacial Carbon Flows – Investigating the Effect of Watermelon Snow on Greenhouse Gases
University of Tennessee researchers test capability of new Lu-mini luminometer during glacial analysis
New Method Reveals How Well Cancer Drugs Hit Their Targets
The findings could help clinicians decide the best course and delivery of treatment for cancer patients
Registration for Lab Innovations 2018 Opens and Keynotes Announced
The UK trade show dedicated to the laboratory industry has launched free advance registration for visitors
Stanford Scientists Advance New Way for Large-Scale Storage of Wind and Solar Power
New type of flow battery more than doubled the maximum voltage of conventional flow batteries and could lead to affordable storage of renewable power
Agilent and Grabner Instruments Provide Innovative Mobile Testing Solution for the Petroleum Industry
Agreement focuses on an innovative mobile testing solution for in-field analysis of lubricating oils and greases
DuPont Nutrition & Health and Eurofins Bring Higher Level of Transparency to Probiotic Industry
Eurofins will use DuPont assays to identify probiotics at the strain level
Nature’s Antifreeze Inspires Revolutionary Bacteria Cryopreservation Technique
The findings could radically improve storage and transportation of human organs, food and medicine – and advance laboratory research
PROGEN Receives Research Award
New Technologies for the Highly Parallel Optimization of Cell Culture Processes
Funding announced for the EU research project iConsensus
SCIEX Supports Cancer Survival Research Through Donation to World Cancer Research Fund
By partnering with WCRF, SCIEX supports research that benefits cancer patients
ZEISS Introduces Machine Learning Capability for Microscopy
First ZEISS ZEN Intellesis solution enables segmentation of correlative microscopy datasets
The MERIT of Working With Microalgae
Algenuity launches multidisciplinary renewables biosynthesis project under Horizon 2020 programme
Wellcome Launches £250m Leap Fund to Place Big Bets on Bold Research
The new fund will finance high-risk, high-reward ideas to drive innovation